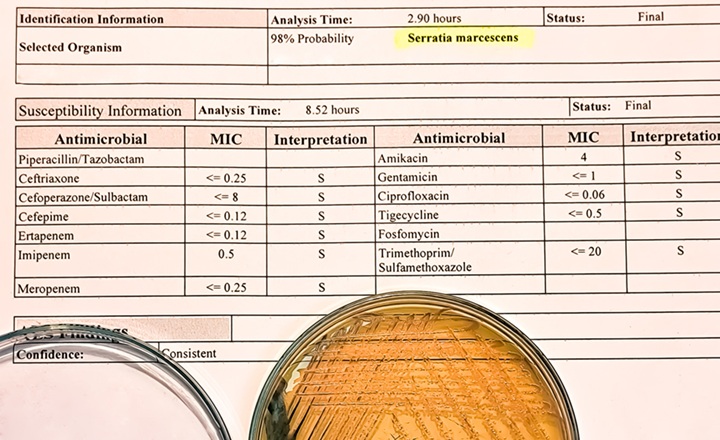
Antimicrobial Susceptibility Testing Challenges of Anaerobes

Why This Matters:
- Anaerobes are clinically important: Anaerobic bacterial infections — such as intra-abdominal, pelvic, brain, and deep soft tissue infections — often require targeted therapy guided by susceptibility data for optimal outcomes. Yet routine AST of anaerobes is less standardized than for aerobes.
- Disk diffusion’s promise and pitfalls: Disk diffusion is inexpensive and widely used in routine labs, but for anaerobes its interpretive criteria and breakpoints have been debated due to variable correlations between zone diameters and MIC values.
- Breakpoint variability: Interpretative breakpoints are set by different standards committees (e.g., CLSI, CA-SFM, EUCAST), and this study shows how applying different criteria to the same dataset can yield different resistance rates. Recognizing these discrepancies is key for reliable AST reporting.
- Clinical impact: Misclassification (major and very major errors) in susceptibility categories can misguide therapy, especially in infections where empirical anaerobic coverage may miss resistant strains.
Key Findings: Comparative breakpoint analysis: The reference MIC dataset for five antibiotics was categorized using CLSI, CA-SFM, and EUCAST disk-diffusion breakpoints, revealing differences in categorized resistance rates depending on which criteria were used.1
- Error rates: The study observed notable major and very major errors when disk diffusion was interpreted under some breakpoint frameworks, underscoring the difficulty of aligning zone diameters with underlying MIC distributions.
- Proposed adjustments: Where misclassification occurred, the authors suggested modified breakpoints that could improve categorical agreement and reduce error rates, potentially leading to more reliable routine AST of anaerobes.
- Methodological context: Despite alternatives like gradient methods or broth microdilution, disk diffusion remains attractive due to simplicity and cost — but must be harmonized with accurate breakpoints to be clinically useful.
Bigger Picture: Routine AST of anaerobes remains a challenge due to their growth requirements and the historical lack of standardized diffusion criteria. This re-analysis underscores that existing disk-diffusion breakpoints can misclassify susceptibility if not appropriately calibrated against robust MIC data. By proposing breakpoint refinements informed by large panels of MIC results and reconciled across standards organizations (CLSI, CA-SFM, EUCAST), this work supports efforts to standardize and improve disk diffusion AST for anaerobes — a step that could enhance treatment accuracy, resistance surveillance, and stewardship in clinical microbiology.
(Image Credit: iStock/ 10174593_258)